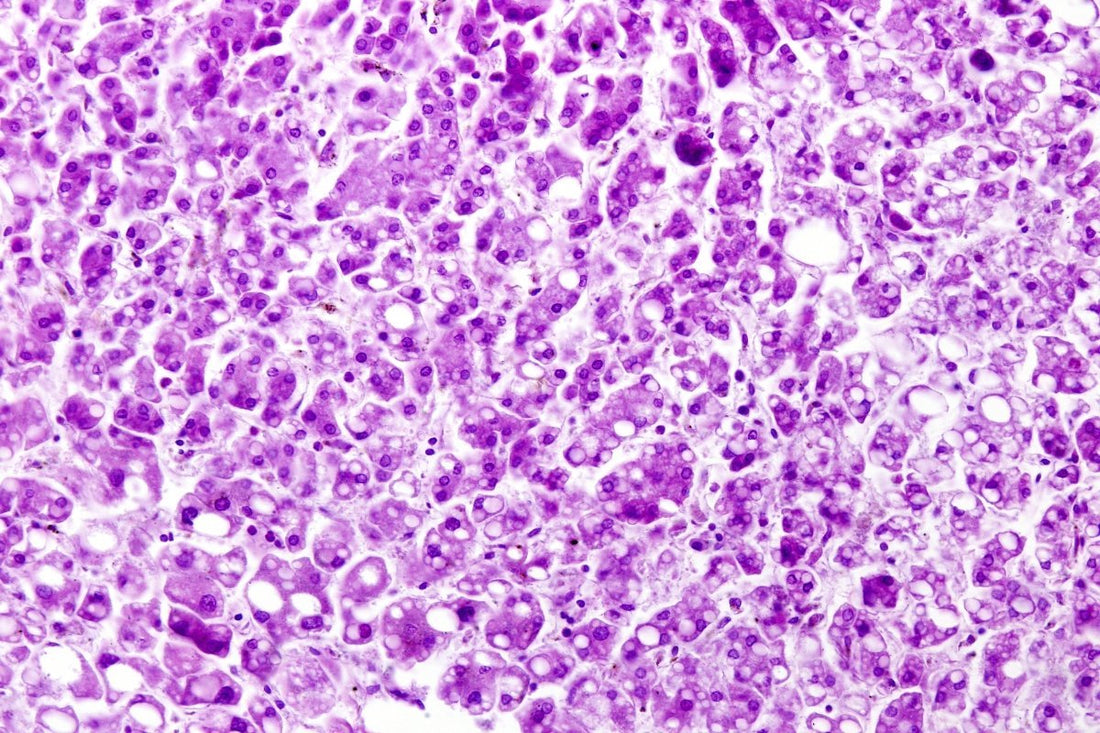

Fegato Grasso: Cause, Sintomi e Rimedi
Condividi con i tuoi amici😉
Il fegato grasso, o steatosi epatica, è una condizione che interessa circa il 25% della popolazione mondiale, spesso in maniera silente. Questo disturbo può evolversi lentamente senza sintomi evidenti, fino a manifestarsi con segnali inequivocabili quando il danno è ormai avanzato. Ma cosa significa realmente avere il fegato grasso e quali sono le migliori strategie per prevenirlo e contrastarlo?

Perché È Importante il Fegato?
Il fegato è l'organo responsabile di funzioni vitali, tra cui:
- Metabolismo dei nutrienti: elabora carboidrati, grassi e proteine.
- Detossificazione: elimina tossine, alcol e residui di farmaci.
- Produzione di bile: essenziale per la digestione dei grassi.
Un fegato in difficoltà compromette l'equilibrio metabolico e l’intero organismo. È quindi fondamentale preservare la salute epatica attraverso uno stile di vita equilibrato.
Le Diverse Tipologie di Steatosi Epatica
1. Steatosi Epatica Non Alcolica (NAFLD)
La forma più comune di fegato grasso è quella non alcolica, associata a:
- Obesità e sovrappeso
- Alimentazione ricca di zuccheri e grassi saturi
- Resistenza all’insulina
2. Steatosi Epatica Alcolica
In questo caso, la causa principale è un consumo eccessivo e regolare di alcol. Il fegato, essendo l'organo che metabolizza l'alcol, accumula grassi per effetto dell’eccessivo carico metabolico.
Cause Scatenanti del Fegato Grasso
1. Alimentazione Ricca di Zuccheri e Grassi Saturi
Le diete squilibrate, ricche di zuccheri semplici, dolci industriali e cibi fritti, favoriscono l'accumulo di grasso nelle cellule epatiche.
2. Sovrappeso e Sindrome Metabolica
Il grasso addominale è strettamente correlato alla steatosi epatica. Un aumento del girovita è un indicatore di rischio.
3. Sedentarietà
L'assenza di movimento riduce la capacità del corpo di bruciare i grassi, favorendo l'accumulo di lipidi anche nel fegato.
Link utile: Secondo la World Health Organization, l'attività fisica regolare può ridurre il rischio di malattie epatiche e metaboliche. Approfondisci qui.
4. Ereditarietà e Genetica
Alcuni individui possono essere più predisposti a sviluppare la steatosi a causa di fattori genetici che influenzano il metabolismo dei grassi.
Sintomi del Fegato Grasso: Come Riconoscerlo
1. Stanchezza Cronica
Una delle prime manifestazioni di un fegato affaticato è la sensazione di stanchezza persistente, anche dopo un sonno adeguato.
2. Dolore o Fastidio Addominale
Il dolore si localizza nella parte superiore destra dell'addome e può essere accompagnato da una sensazione di pesantezza.
3. Nausea e Malessere
Un fegato sovraccarico può influenzare il processo digestivo, causando nausea, gonfiore e digestione lenta.
Diagnosi della Steatosi Epatica
Per diagnosticare correttamente il fegato grasso, i medici si avvalgono di diversi strumenti:
1. Esami del Sangue
La presenza di enzimi epatici elevati (ALT e AST) è spesso un primo campanello d’allarme.
2. Ecografia Addominale
Questo esame non invasivo permette di rilevare la presenza di grasso nel fegato.
3. Biopsia Epatiche
In casi complessi, una biopsia può essere effettuata per valutare la gravità dell’infiammazione e delle eventuali cicatrici.
Link autorevole: La Mayo Clinic sottolinea che una diagnosi tempestiva può prevenire complicazioni gravi. Leggi di più qui.
Complicazioni del Fegato Grasso
1. Steatoepatite Non Alcolica (NASH)
La NASH è una forma più grave di fegato grasso che include infiammazione e danni alle cellule epatiche.
2. Cirrosi Epatica
Quando il fegato subisce danni prolungati, il tessuto epatico normale viene sostituito da tessuto cicatriziale, compromettendo la funzionalità epatica.

Strategie per Contrastare il Fegato Grasso
1. Migliorare l'Alimentazione
Seguire una dieta equilibrata ricca di:
- Verdure a foglia verde
- Legumi e cereali integrali
- Fonti di proteine magre come pollo e pesce
- Grassi buoni, come quelli contenuti nell’avocado e nell’olio extravergine d’oliva
2. Riduzione degli Zuccheri Raffinati
Evitare bevande zuccherate e dolci industriali riduce significativamente l’accumulo di grasso epatico.
3. Attività Fisica Costante
Anche 150 minuti di camminata veloce a settimana possono migliorare i parametri metabolici e ridurre il grasso viscerale.
Integratori per il Benessere del Fegato
Alcuni integratori possono sostenere la salute epatica, come:
- Curcumina: con proprietà antiossidanti e antinfiammatorie.
- Silimarina (estratta dal cardo mariano): aiuta a proteggere le cellule epatiche.
- Vitamina E: indicata per ridurre l'infiammazione nelle persone con NAFLD.
Se vuoi conoscere integratori studiati per sostenere la salute epatica, visita Centiure per scoprire i prodotti migliori per il tuo benessere.
Prevenzione: Piccoli Cambiamenti, Grandi Risultati
- Evita gli alcolici o consumali con moderazione.
- Fai esercizio fisico almeno tre volte a settimana.
- Riduci al minimo l'assunzione di zuccheri semplici e alimenti ultra processati.
- Consulta regolarmente il tuo medico per monitorare i parametri epatici.
Il Ruolo dell’Infiammazione nel Fegato Grasso
Come l’infiammazione influenza il fegato
L'infiammazione cronica è una delle principali cause di progressione del fegato grasso verso forme più gravi, come la steatoepatite. Quando il fegato è sovraccarico di grasso, le cellule epatiche rilasciano molecole pro-infiammatorie che peggiorano la salute complessiva dell'organo.
L'importanza di una dieta anti-infiammatoria
Una dieta povera di cibi trasformati e ricca di alimenti naturali contribuisce a ridurre l'infiammazione. Inserire alimenti come mirtilli, salmone, curcuma e tè verde può fare la differenza nel rallentare i processi infiammatori.
Il Fegato e il Rapporto con lo Stress
Come lo stress impatta la salute del fegato
Lo stress prolungato può influire sui livelli di cortisolo, un ormone che, se presente in quantità elevate, contribuisce all'accumulo di grasso nel fegato. L'incremento del cortisolo promuove l'aumento di glucosio nel sangue e stimola la produzione di grassi epatici.
Strategie per gestire lo stress
- Praticare la respirazione profonda e la meditazione.
- Fare attività fisica regolare.
- Dormire almeno 7-8 ore per notte.
Ridurre lo stress quotidiano aiuta a mantenere stabili i parametri epatici.
Fegato Grasso e Resistenza all’Insulina
Cos’è la resistenza all’insulina
La resistenza all'insulina si verifica quando le cellule del corpo non rispondono correttamente all'insulina, causando livelli elevati di zucchero nel sangue. Il fegato, per compensare, accumula grasso, peggiorando la situazione.
Perché la resistenza all'insulina peggiora la steatosi
In presenza di glicemia alta, il fegato lavora di più per convertire il glucosio in grassi. Questo processo porta all'accumulo di trigliceridi, aggravando il quadro clinico del fegato grasso.
Il Ruolo delle Fibre nella Salute Epatica
Fibre solubili e insolubili: perché sono importanti
Le fibre solubili (presenti in avena, mele e semi di lino) rallentano l'assorbimento degli zuccheri, mentre le fibre insolubili (cereali integrali, verdure a foglia verde) favoriscono la regolarità intestinale.
Come le fibre riducono l'accumulo di grasso nel fegato
Un consumo regolare di fibre aiuta a mantenere sotto controllo i picchi glicemici e riduce l'assorbimento di grassi a livello intestinale, contribuendo alla salute epatica.
Il Fegato Grasso e l’Impatto del Sonno
La connessione tra sonno e metabolismo epatico
Uno scarso riposo notturno può compromettere la capacità del fegato di metabolizzare correttamente i nutrienti e favorire l'accumulo di grassi. Inoltre, la privazione del sonno aumenta la produzione di cortisolo, peggiorando l’infiammazione epatica.
Migliorare il sonno per supportare il fegato
- Evitare cene abbondanti prima di dormire.
- Limitare l’uso di dispositivi elettronici nelle ore serali.
- Mantenere una routine regolare di sonno e veglia.
L'Importanza degli Acidi Grassi Omega-3
Come gli Omega-3 proteggono il fegato
Gli acidi grassi Omega-3, presenti nel salmone, nelle noci e nei semi di chia, hanno proprietà antinfiammatorie e contribuiscono a ridurre l'accumulo di trigliceridi nel fegato.
Integrazione di Omega-3
Per chi non riesce a consumare pesce frequentemente, l'integrazione con olio di pesce può rappresentare un'opzione efficace per mantenere il fegato in salute.

L’Alcol e il Fegato Grasso
Il legame tra alcol e steatosi epatica
Il consumo eccessivo di alcol è una delle principali cause della steatosi epatica alcolica. L’alcol viene metabolizzato quasi esclusivamente dal fegato e, in quantità elevate, può causare danni permanenti alle cellule epatiche.
Come ridurre l’assunzione di alcol
- Preferire bevande analcoliche durante i pasti.
- Evitare il consumo quotidiano di bevande alcoliche.
- Stabilire "giorni senza alcol" durante la settimana.
Il Ruolo della Vitamina D nella Salute Epatica
Perché la Vitamina D è importante per il fegato
La vitamina D ha un ruolo chiave nella modulazione del sistema immunitario e può contribuire a ridurre l'infiammazione epatica. Uno scarso livello di vitamina D è spesso correlato a un peggioramento della steatosi epatica.
Fonti naturali di Vitamina D
Esporsi al sole per almeno 15-20 minuti al giorno e consumare alimenti ricchi di vitamina D, come salmone, uova e funghi, aiuta a mantenere livelli adeguati di questa vitamina.
La Perdita di Peso e il Miglioramento del Fegato
Perché perdere peso aiuta il fegato
Perdere anche solo il 5-10% del peso corporeo può ridurre significativamente l’accumulo di grasso nel fegato, migliorando i livelli di enzimi epatici.
Strategie per una perdita di peso graduale
- Seguire una dieta bilanciata con un deficit calorico moderato.
- Evitare diete estreme che causano effetti "yo-yo".
- Associare un’attività fisica regolare.
Il Monitoraggio Regolare della Salute Epatica
Quando fare i controlli epatici
Sottoporsi a controlli annuali per verificare i livelli degli enzimi epatici e monitorare il profilo lipidico aiuta a identificare eventuali problematiche in fase iniziale.
Esami del sangue consigliati
- ALT e AST (enzimi epatici)
- Gamma GT
- Bilirubina
Conclusioni
Il fegato grasso è una condizione che può essere gestita e, in molti casi, migliorata con uno stile di vita sano. La prevenzione è l'arma migliore: una dieta equilibrata, l'attività fisica e controlli regolari sono fondamentali per preservare il benessere del fegato.
Se sei pronto a prenderti cura del tuo organismo in modo completo, visita il sito di Centiure e scopri come nutrire il tuo benessere a partire dal fegato.